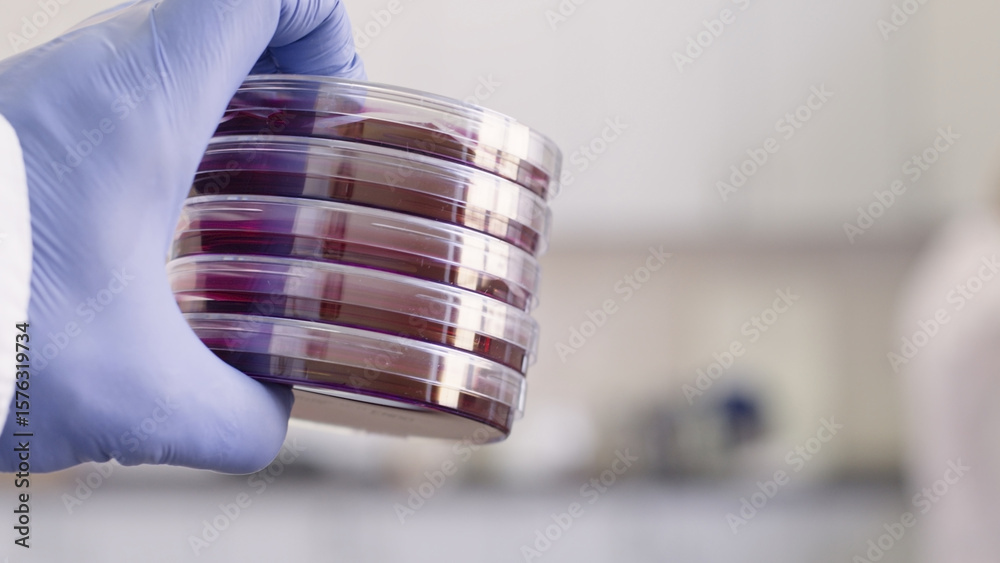

-
Brendovi & Merch
- Filmski plakati
- Batman
- Spider-Man
- Star Wars
- Harry Potter
- MARVEL
- DISNEY
- Pokemon
- Prikaži sve
- Glazbeni posteri
- Queen
- Rolling Stones
- AC/DC
- The Beatles
- Bob Marley
- Iron Maiden
- Metallica
- Prikaži sve
- Anime & Manga
- Attack on Titan
- Pokemon
- Demon Slayer
- Jujutsu Kaisen
- Death Note
- Dragon Ball Z
- My Hero Academia
- Prikaži sve
- Stripovi
- Batman
- Spider-Man
- Superman
- Kapetan Amerika
- Osvetnici
- MARVEL
- Wonder Woman
- Prikaži sve
- Gamer posteri
- Assassin's Creed
- Nintendo
- Playstation
- Online igre
- Xbox
- Minecraft
- Sonic
- Prikaži sve
- Posteri za djecu
- Harry Potter
- Minecraft
- Lilo & Stitch
- DISNEY
- Snježno kraljevstvo
- Mickey Mouse
- Princezna
- Prikaži sve
-
Umjetnički printevi
- Prema žanru
- Apstraktna ilustracija
- Crno bijeli tonovi
- Putnički plakati
- Citati i tekstovi
- Dodir prirode
- Kolažna umjetnost
- Line Art
- Man Cave
- Moda
- Motivi za djecu
- Romantika
- Sportska ilustracija
- Magazine Cover
- Women Power
- Životinje
- Svakodnevna inspiracija za vaš dom ili ured
- Po stilu
- Bauhaus
- Eko stil
- Retro & Vintage
- Azijska atmosfera
- Skandinavski stil
- Art Deco stil
- Boho stil
- Pariška elegancija
- Tropski raj
- Pop art stil
- Provansalski stil
- Harmonija i mir
- Stil romantičnog dvorca
- Industrijski stil
-
Slike
- Slike na platnu
- Slike na platnu
- Multipart platna
- Slike na platnu -60 %%
- Prikaži sve
- Slike
- Foto pokloni
- Multipart platna
- Reprodukcije
- Uokvirivanje – okviri i kukice
- Uramljeni plakati -20 %%
- Reprodukcije
- Florent Bodart
- Paul Cezanne
- Claude Monet
- Pierre-Auguste Renoir
- Sam Toft
- Leonardo da Vinci
- Alphonse Mucha
- Hieronymus Bosch
- Gustav Klimt
- Wassily Kandinsky
- Leonetto Cappiello
- Vincent van Gogh
- Katsushika Hokusai
- Prikaži sve
-
Fotografije
- Fotografije
- Ispis vaših fotografija
- Najpopularnije
- TOP Fotografija
- Trending
- Umjetnički fotografi
- Prikaži sve
- Prema žanru
- Crno-bijela elegancija
- Životinje
- Priroda & krajolik
- Put oko svijeta
- Dokaz ljubavi
- Svakodnevnica
- Makro
- Egzotična avantura
- Ljepota minimalizma
- Old school
- Panorama
- Ukusan svijet
- Vibre planina
- Pogled odozgo
-
Posteri
- Uokvirivanje – okviri i kukice
- Okviri na zalihama
- Trake za postere
- Dodaci
- Zidne dekoracije
- Metalni znakovi
- Set plakata
- Plakati i tapete za vrata
- Naljepnice za namještaj
- XXL Veliki plakati
- Panorama
- Uramljeni plakati -20 %%
- Brendovi & Merch
- Filmski plakati
- Glazbeni posteri
- Anime & Manga
- Stripovi
- Gamer posteri
- Posteri za djecu
- Sportovi
- Slavne osobe
- Posteri
- Najpopularnije - TOP
- Novosti
- Ispis vaših fotografija
- Brendovi & Merch
- Posljednja prilika -60 %%
- Popusti do -80 %%
- Zidne dekoracije
- Uokvirivanje – okviri i kukice
- Motivi
- Apstraktnost
- Arhitektura
- Auto - Moto - Aero
- Crno i bijelo - Black & White
- Edukativni posteri - Škola
- Erotični posteri
- Fantasy & Mystery
- Hrana & Piće
- Moda
- Motivacijski plakati i citati
- Povijest i religija
- Priroda & Pejzaž
- Putovanja
- Reprodukcije
- Romantika
- Slavne osobe
- Smiješni plakati
- Sportovi
- Svemir
- Svjetske metropole & Gradovi
- Tulumi, Slavlja, Blagdani
- Umjetnički printevi
- Za firmu
- Zastave
- Zemljovidi
- Životinje
-
Foto tapete
- Foto tapete -60 %%
- Najpopularnije
- Naljepnice
- Odabir dizajnera
- Filmske zidne tapete
- Superheroji
- Animirani
- TV Serije
- Fantazija
- Zidne tapete prema žanru
- Auto - Moto - Aero
- Svemir
- 3D Posteri & Zidni murali
- Arhitektura
- Teme igara
- Glazbeni zidni murali
- Zemljovidi svijeta
- Motivi za djecu
- Priroda & Pejzaž
- Umjetnička zidna tapeta
- Uzorci i ukrasi
- Životinje
-
-20 %Kalendari 2026
- 3D kalendari
- Advent Kalendar
- Kalendari - Automobili
- Kalendari - Erotični
- Kalendari - Film & TV
- Kalendari - Gamer
- Kalendari - Glazba
- Kalendari - Gradovi
- Kalendari - Ličnosti
- Kalendari - Retro i vintage
- Kalendari - Spiritualni
- Kalendari - Sport
- Kalendari - Umjetnici
- Kalendari - Životinje
- Priroda - Putovanja
- 3D kalendari
- Advent Kalendar
- Kalendari - Automobili
- Kalendari - Erotični
- Kalendari - Film & TV
- Kalendari - Gamer
- Kalendari - Glazba
- Kalendari - Gradovi
- Kalendari - Ličnosti
- Kalendari - Retro i vintage
- Kalendari - Spiritualni
- Kalendari - Sport
- Kalendari - Umjetnici
- Kalendari - Životinje
- Priroda - Putovanja
- Prikaži sve
-
Šalice & Posuđe
- Posuđe
- Metalne kutije & kutije za ručak
- Boce
- Otvarači za boce
- Podmetači
- Čaše
- Čašice i pljoske
- Tanjuri & Zdjelice
- Posuđe po motivu
- Anime posuđe
- Auto-moto posuđe
- Retro posuđe
- Posuđe poznatih umjetnika
- Fantastične posuđe
- Film & TV
- Fotografije
- Posuđe videoigara
- Posuđe za djecu
- Glazba
- Stripovi
- Sportsko posuđe
- Humor posuđe
- Novosti
-
Odjeća
- Odjeća
- Hoodies i džemperi
- Kape i šeširi
- Zimska odjeća
- Čarape
- Hlače
- Pidžame i pribor za spavanje
- Kućni ogrtači & Ručnici
- Torbe & Ruksaci
- Novčanici
- Nakit i kozmetički dodaci
- Kišobrani
- Rukavi za gaming
- Donje rublje
- Novosti
- Majice & Topovi
- Ženske majice
- Muške majice
- Dječje majice
- Majice – Naša kolekcija
- Majica s fotografijom
- Majice -60 %%
- Majice po brendovima
- Glazbene majice
- Anime majice
- Filmske i TV majice
- Gaming majice
- Harry Potter
- Star Wars
- Gospodar prstenova
- MARVEL
- Batman
- Majice po motivu
- Majice slavnih umjetnika
- Majice sa sportskim motivima
- Apstraktne majice
- Majice s azijskim motivima
- Majice s Line Art
- Majice hrana & piće
- Majice sa životinjama
- Majice Auto Moto
- Majice s dječjim motivima
- Majice sa zastavama
- Smiješne majice
- Majice s citatima
- Bauhaus majice
- Pop Art majice
- Podrška Ukrajini
-
Majice & Topovi
- Hoodies i džemperi
-
Kape i šeširi
-
Zimska odjeća
- Čarape
- Hlače
- Pidžame i pribor za spavanje
- Kućni ogrtači & Ručnici
-
Torbe & Ruksaci
-
Novčanici
-
Nakit i kozmetički dodaci
- Kišobrani
- Rukavi za gaming
-
Moda iz filmova
-
Odjeća za:
- Donje rublje
- Novosti
- Prikaži sve
-
 Majice – Naša kolekcija
Majice – Naša kolekcija
 Ženske majice
Ženske majice
 Muške majice
Muške majice
 Glazbene majice
Glazbene majice
 Filmske i TV majice
Filmske i TV majice
 Gaming majice
Gaming majice
-
Pokloni & Igre
- Pokloni & Igre
- Foto pokloni
- Igračke
- Poklon bon
- Savršeni pokloni za
- Božić
- Pokloni za muškarce
- Pokloni za ženu
- Pokloni za djecu
- Darovi za parove
- Pokloni za kolekcionare
- Pokloni za učenike
- Pokloni za životinje
- Merch
- Licencirani dodaci za dom
- Metalni znakovi
- Poklon setovi
- Maleni & jeftini pokloni
- Figurice
- Kolekcionarske replike
- Igračke
- Šalice & Posuđe
- Kalendari 2026 -20 %%
- Ured & Školski pribor
- Limeni retro pokloni
- Slagalice
- Torbe & Ruksaci
- Rokovnici
- Likovni materijali
- Uramljeni plakati -20 %%
- Igračke
- Lutke
- MGA's Miniverse
- LEGO
- Plišane igračke
- Akcijske figure i igračke
- Modeli automobila
- CarTuned
- Hot Wheels
- Karte za igru
- NERF
- Društvene igre
- Slikovne kocke
-
Za firmu
- Za firmu
- Ljepota i zdravlje
- Studio za vjenčanja
- Ugostiteljstvo
- Liječnici
- Edukativni posteri - Škola
- Fitness studio
- Heroji ulice
- Ured
- Profesionalci i poslovni ljudi
- B2B Partners
- Ljepota i zdravlje
- Kozmetički studio
- Studio za tetoviranje
- Brijačnica
- Wellness & Spa
- Frizerski salon
- Manikura
- Fitness studio
- Teretana & Fitness
- Sportska estetika
- Sportska ilustracija
- Automobilist
- Joga
- Ples
- Nogomet
- Okviri & Uokvirivanje
- Foto pokloni

Boje dobivenog ispisa možda neće uvijek odgovarati bojama na Vašem zaslonu.
Naljepnica A stack of Petri dishes with red ENDO medium in a scientist's hand, close-up od Prrrettty
 4.7 3 816 recenzija
4.7 3 816 recenzija
Odaberite dodatne opcije ispisa
Opis proizvoda
Naljepnica
Naljepnice su originalne i višefunkcionalne. Mogu se koristiti kao plakat ili tapeta na zidu, ili kao naljepnica za namještaj ili vrata. Lako se nanose – jednostavno zalijepite i skinite bez upotrebe ljepila. Ne ostavljaju mrlje na zidu. Mogu se lako obrezati škarama na bilo koji oblik i mogu se čistiti vlažnom krpom. Za tisak naljepnica koristimo visokokvalitetne, 100% ekološke boje koje su prikladne čak i za dječje sobe.Platno je pažljivo napeto na čvrst drveni okvir, dostupan u dvije dubine – 2 cm za nježniji izgled ili 4 cm za izraženiji efekt. Visokokvalitetni materijali i precizna izrada osiguravaju dugotrajnu izdržljivost. Platnena slika odličan je izbor i stilski ukras za svaki interijer.
Recenzije i iskustva kupaca

4.7 / 5
(3 816 recenzija)
Prikazane recenzije za: Fotografija
Sudjelujte u Instagram foto natječaju i osvojite vaučer od 40 €!


1. Učitajte svoju fotografiju na Instagram.
2. Označite naš profil:
@europosters.merch.
3. Osvojite!
Dobitnik se izvlači svakog mjeseca. Držimo palčeve!
Kontakt
Europosters, s.r.o.
E-mail: info@europosters.eu
Tel.: +420 210 440 210
(samo na engleskom)
Ponedjeljak – Petak ǀ 7:00–17:00
Europosteri – Stvaram svoj svijet
Od 1999. Europosteri su jedna od najvećih web trgovina plakata, zidnih grafika i darova s licenciranom robom u Češkoj i cijeloj Europi. Nudimo ogroman izbor plakata iz filmove, igara ili sportova svih veličina, kao i široku paletu originalnih poklona za istinske ljubitelje Ratova zvijezda, Harryja Pottera, stripova ili cijele obitelji Warner Bros. Znamo da su šalice, figurice, puzzle i odjeća najbolji poklon za sve, bez obzira na dob i interes. Ali ako ste ljubitelj dizajna interijera, onda ste i Vi na pravom mjestu! Svakodnevno ispisujemo zidne tapete, ilustracije, fotografije i umjetničke reprodukcije i šaljemo ih u više od 25 zemalja kako bi naši kupci bili zadovoljni.
© 1999–2025 Europosters. Sva prava pridržana.









































































